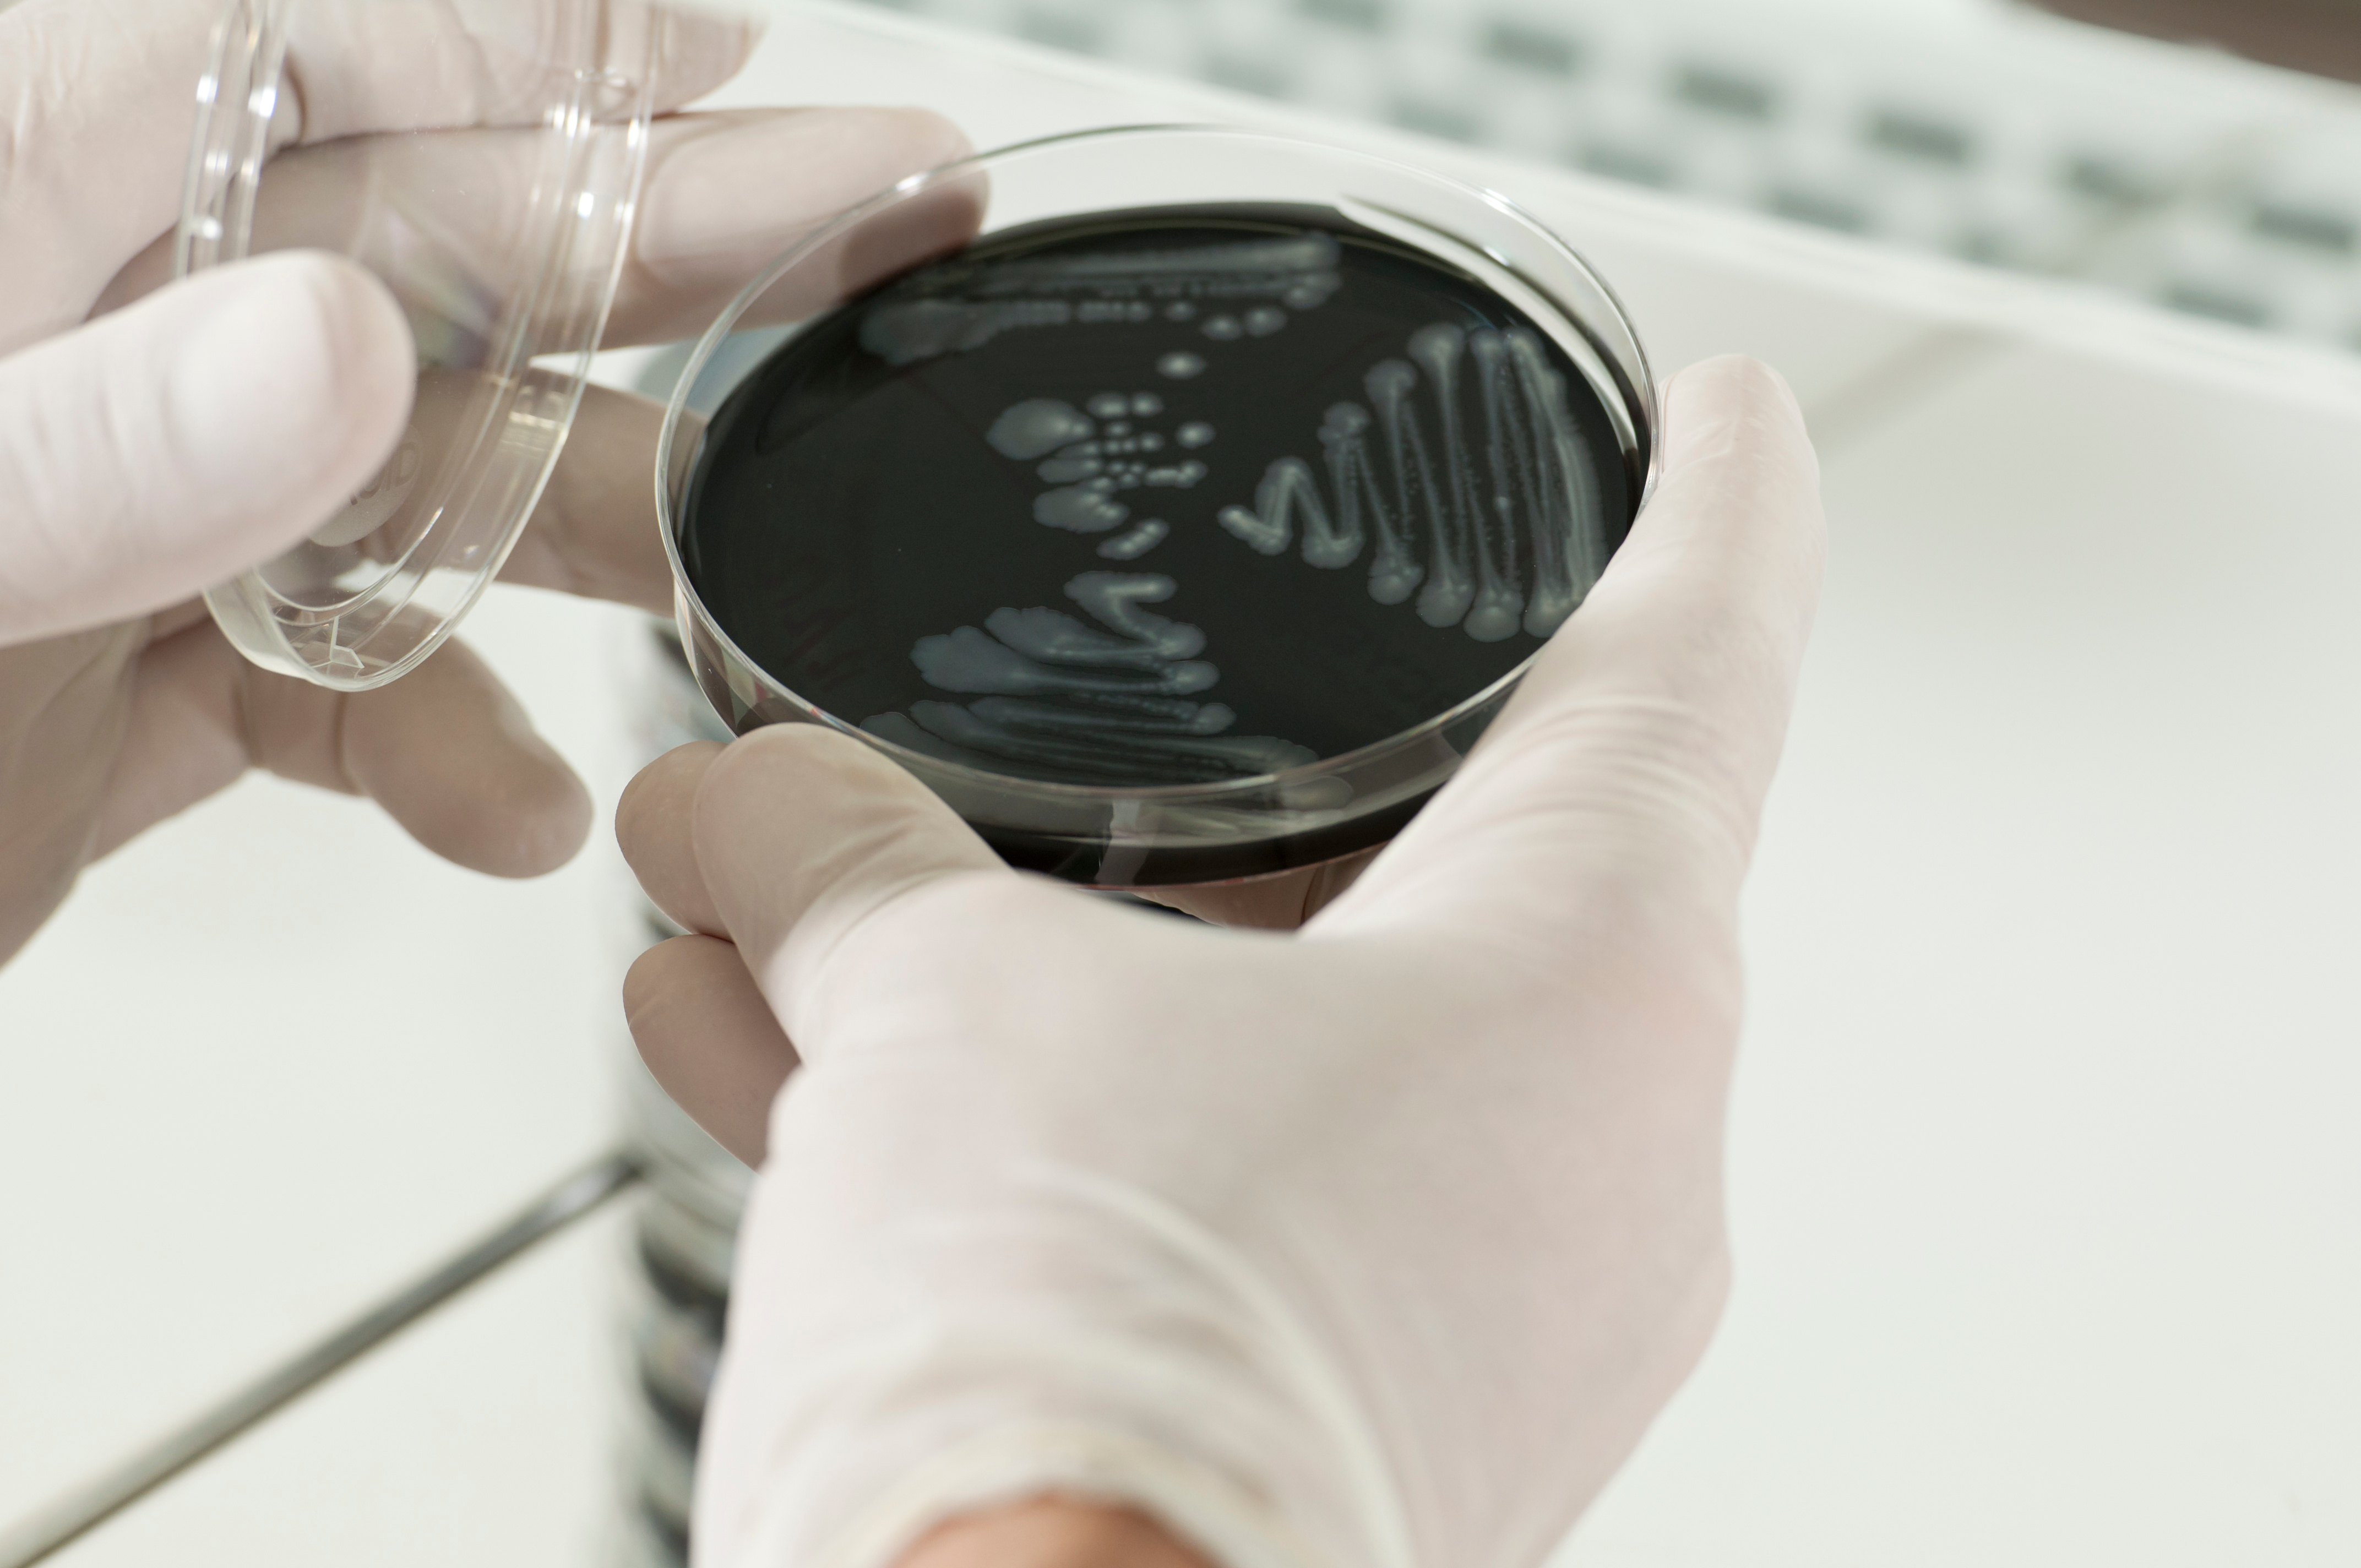
Legionella Testing

Our experts at ECT Water Microbiology offer professional, cost-effective Legionella testing services to help clients monitor the risk of Legionnaires’ disease in their building and ensure compliance with HSE ACOP L8 and HSG274.
Importance of Legionella Testing
Legionella is a type of bacteria that can be found in various natural water sources, where it occurs in relatively low numbers. It poses little threat to human health until the water temperature reaches between 20°C and 45°C, at which point the bacteria can grow to dangerous levels.
When this contaminated water is aerosolised, such as during shower use, Legionella can be inhaled into the lungs and go on to cause a severe form of pneumonia known as Legionnaires’ disease.

Water systems most at risk include:
- Showers, sprinklers & vehicle wash systems
- Fountains & water features
- Hot & cold-water systems
- Cooling water systems, cooling towers & evaporative condensers
- Spray humidifiers, misters, air washers & wet scrubbers
- Spa pools
- Any other system containing water in which Legionella could grow & be released in aerosol droplets

Our Legionella Testing Services
At ECT Water Microbiology, we are UKAS*-accredited to the most up-to-date BS EN ISO 11731:2017 using standard culture methods. Legionella pneumophila is the key species in most cases, which we can detect to 20cfu in a 1-litre sample.
What Businesses Are Considered High Risk for Legionella?
Legionella thrives in warm water environments with available nutrients, such as scale, sediment, rust, algae, sludge, or even stagnant water, which allow the bacteria to multiply.
- Hotels & restaurants
Commercial buildings
Hospitals & care homes
Dental practices
Residential complexes
Schools, colleges & universities
Industrial companies (air-conditioning & cooling towers)
Sports halls, swimming pools, spas & saunas
Shipping
* For a full list of our UKAS-accredited activities, please view our schedule of accreditation.

ECT Water Microbiology for Legionella Testing
Regular Legionella testing is proven to mitigate the risk of Legionella contamination, helping organisations of all kinds keep everyone safe and healthy.
These investigations must be conducted by a competent person who has had adequate training. The ECT Water Microbiology team is fully qualified to carry out Legionella testing.
It is recommended to test for Legionella contamination when:
- A water system is suspected or identified in a case of an outbreak of Legionnaires’ disease
- A water system is being treated with biocides & hot water is stored / distributed at lower temperatures
- The limits of a control regime are not being consistently achieved (e.g., temperature or disinfectant concentrations)
- There is a high-risk area or population with increased susceptibility (e.g., care homes)